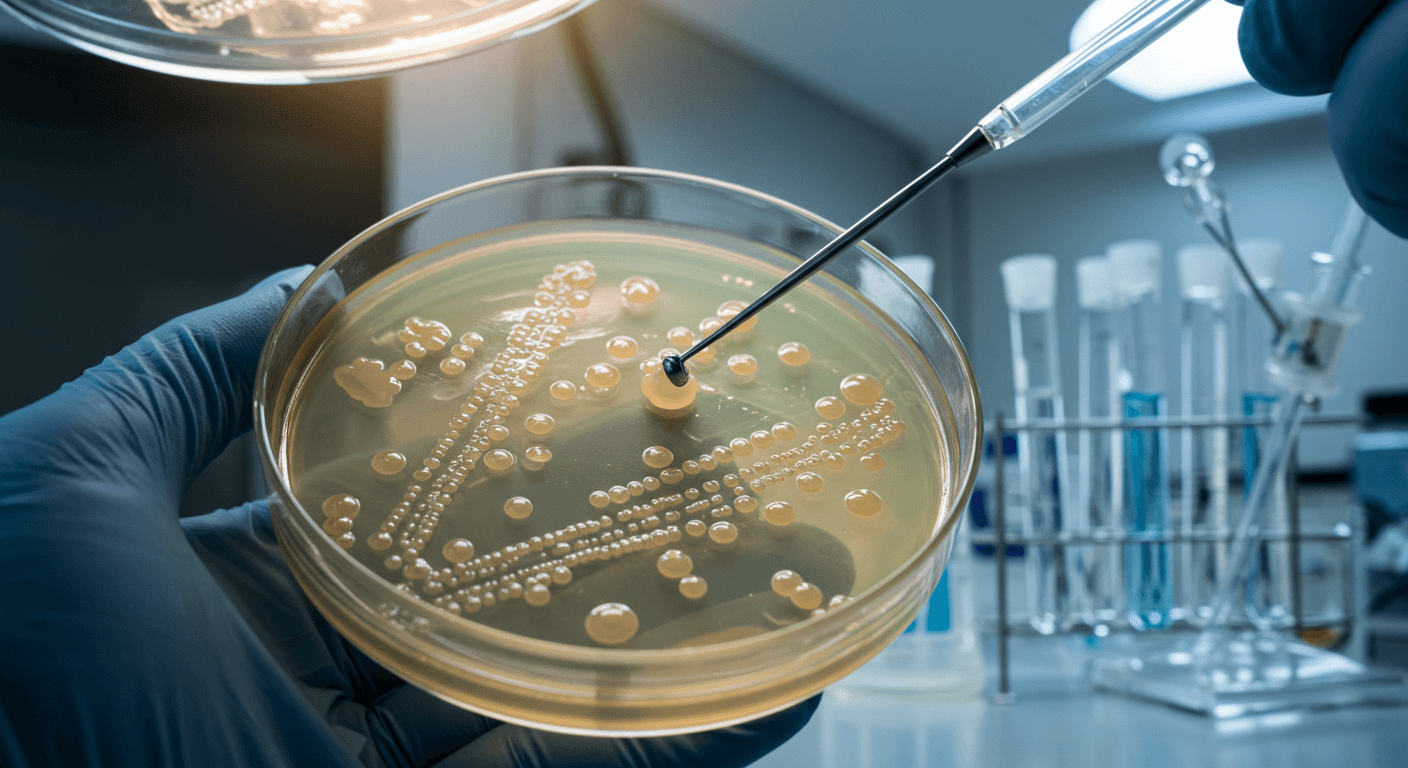
베트남 홍역 유행 지역과 홍역 증상
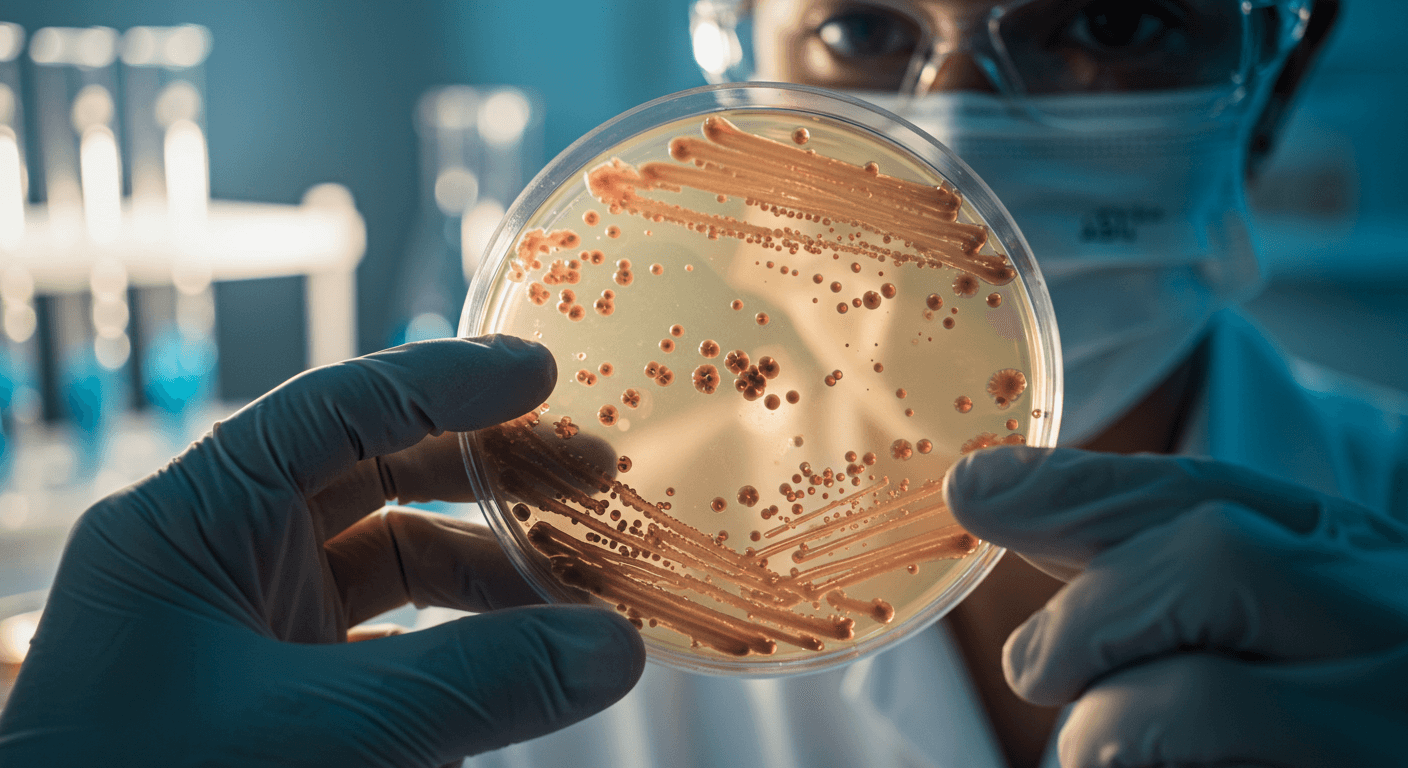
베트남 홍역 유행 지역과 홍역 증상
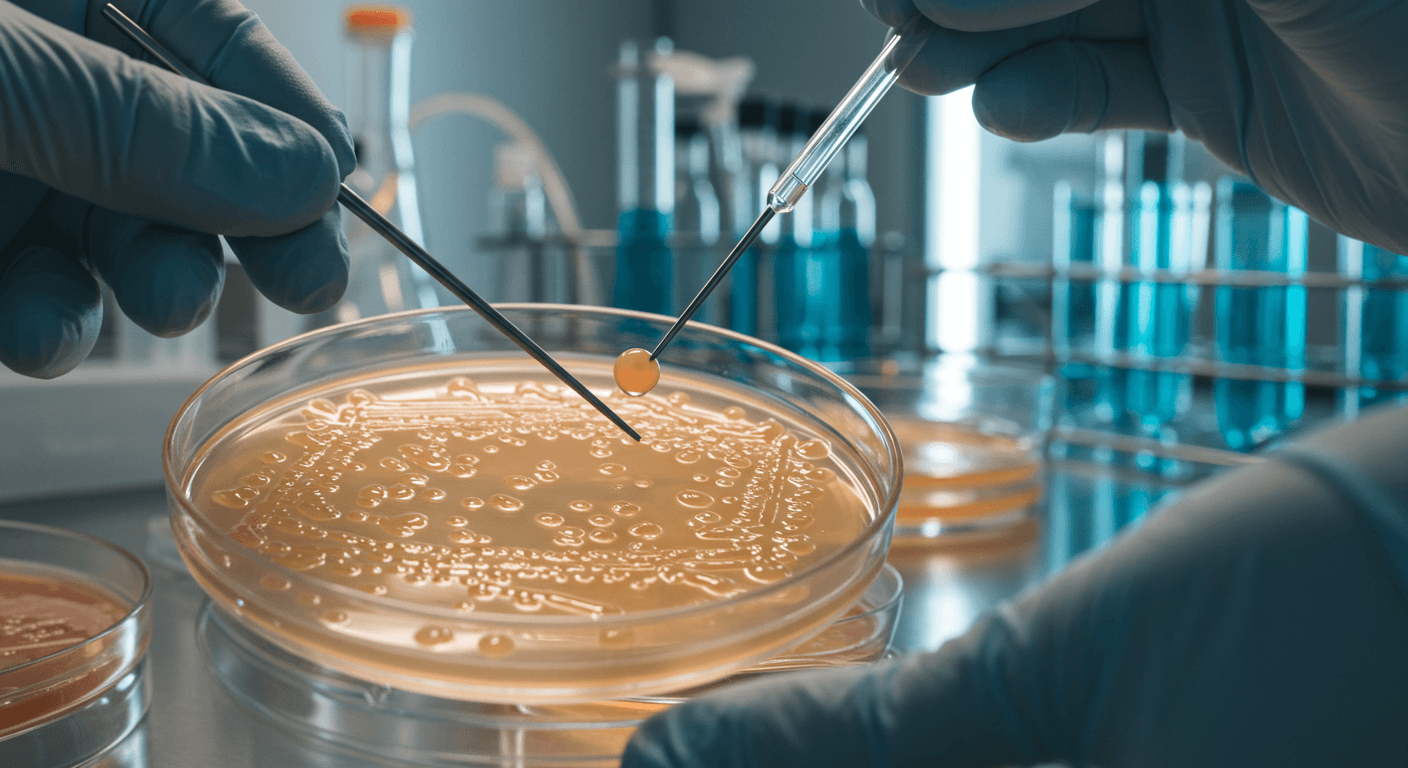
베트남 홍역 유행 지역과 홍역 증상

티스토리 뷰
목차
베트남에서 홍역 감염자가 급증하고 있습니다. 베트남을 방문할 예정이라면 홍역 유행지역과 홍역 증상, 여행 시 주의사항까지 꼭 확인하세요!
🌍 베트남 홍역 유행지역 현황
홍역은 한 명의 환자가 평균 12~18명에게 전파시킬 수 있는 전염성 강한 위험한 바이러스입니다. 최근 백신 접종률이 낮은 베트남 지역을 중심으로 확산되고 있으며, 한국인 관광객과 유학생 감염 사례도 보고되고 있습니다. 베트남을 방문하실 분들은 아래 유행지역 정보를 확인하시기 바랍니다.
📍 호치민시 (Ho Chi Minh City)
- 감염자 수: 1,260명 이상
- 호치민시는 베트남 내에서 가장 많은 홍역 감염자가 발생한 지역입니다.
- 유치원, 초등학교, 이주노동자 밀집지역을 중심으로 빠르게 확산되고 있습니다.
- 대형 쇼핑몰, 지하철, 공항 등 밀집된 실내 공간을 이용하실 때는 KF94 이상의 마스크를 착용해주시기 바랍니다.
- 외출 후 손 씻기와 손 소독을 생활화해 주셔야 합니다.
📍 하노이 (Hanoi)
- 감염자 수: 약 840명
- 하노이 지역은 백신 접종률 저하와 일부 지역의 보건 인프라 부족으로 인해 성인 감염자도 증가하고 있습니다.
- 지역 축제나 야외 공연 등 다중이 모이는 장소는 가급적 피하시는 것이 좋습니다.
- 여행 중 증상이 발생한 경우 즉시 의료기관을 방문하시고, 귀국 후에도 3주간 건강 상태를 주의 깊게 관찰하셔야 합니다.
📍 다낭 (Da Nang)
- 감염자 수: 530명
- 외국인 관광객이 자주 찾는 해변과 호텔, 공항 등에서 감염이 이어지고 있습니다.
- 실내 수영장, 스파, 마사지샵 등의 밀폐 공간을 이용하실 때는 위생상태를 꼼꼼히 확인하시는 것이 필요합니다.
- 다낭을 방문하시는 경우, 반드시 손소독제와 개인용 위생용품을 챙겨 다니셔야 합니다.

📍 하이퐁 (Hai Phong)
- 감염자 수: 370명
- 항만과 산업단지 주변 기숙사에서 집단 감염이 발생한 지역입니다.
- 산업 현장 또는 외국인 선원과의 접촉 가능성이 있는 장소는 방문을 자제해 주시기 바랍니다.
- 하이퐁 방문 후 고열이나 기침이 동반될 경우 즉시 병원 진료를 받으셔야 합니다.
📍 껀터 (Can Tho)
- 감염자 수: 260명
- 농촌 지역으로 의료접근성이 낮아 지역사회 감염이 심화되고 있습니다.
- 이 지역에서는 아동 및 노약자와의 접촉을 피하고 개인 위생 수칙을 철저히 지켜야 합니다.
⚠️ 유행지역 방문 시 주의사항

✔MMR 백신 2회 접종 여부 확인
: 출국 전 MMR 백신을 2회 모두 접종했는지 확인해 주세요. 미접종자는 최소 2주 전에 접종을 완료하셔야 합니다.
✔마스크 착용과 손 위생 생활화
: KF94 이상의 마스크를 반드시 착용해주시고, 외출 후에는 손 씻기와 알코올 손소독제를 사용해 주세요.
✔밀집 장소 회피
: 시장, 축제, 공연, 대중교통 등 많은 사람이 모이는 공간은 최대한 피하셔야 합니다.
✔귀국 후 증상 발생 시 즉시 병원 방문
: 귀국 후 3주 이내 고열, 기침, 발진 등의 증상이 나타날 경우 반드시 보건소나 병원에 알리고 진료를 받으셔야 합니다.
✔면역 저하자 및 임산부는 여행 자제 권고
: 면역력이 약한 분들, 만 5세 미만 아동, 임산부는 베트남 유행지역 방문을 자제하시는 것이 바람직합니다.
🤒 홍역의 증상 및 경과

🧬 1단계: 잠복기 (7~14일)
: 홍역 바이러스에 노출된 뒤 약 1~2주 동안은 특별한 증상이 나타나지 않습니다. 하지만 이 시기에도 이미 다른 사람에게 바이러스를 전파할 수 있기 때문에 주의가 필요합니다. 해외 방문 후 증상이 없어도 가족이나 주변인과의 밀접한 접촉은 피하셔야 합니다.
🔥 2단계: 전구기 (3~5일)
: 고열(38도 이상), 기침, 콧물, 결막 충혈 등의 증상이 발생합니다. 감기처럼 보이지만, 입 안에 ‘코플릭 반점’이라는 하얀색 반점이 나타나면 홍역일 가능성이 높습니다. 이 시기의 전염력이 가장 강하므로 외출을 자제하고 의료기관을 이용하시기 바랍니다.
🌕 3단계: 발진기 (4~7일차)
: 얼굴에서 시작된 붉은 반점이 점차 목, 팔, 몸통, 다리로 퍼집니다. 발진이 나타나기 직전부터 이미 전염력이 있으므로, 집 안에서도 마스크를 착용하고 격리하는 것이 중요합니다. 고열이 지속되고 기운이 없으며, 눈물이 나고 빛에 예민해질 수 있습니다.
🧠 4단계: 회복기 또는 합병증기 (1~3주)
: 고열과 발진이 가라앉으며 증상이 호전되기 시작합니다. 그러나 일부 환자에게는 폐렴, 중이염, 뇌염 등의 합병증이 발생할 수 있어 반드시 정기적인 관찰이 필요합니다. 특히 5세 미만 아동과 30세 이상 성인은 중증으로 악화될 수 있으므로 치료 중에도 신속한 대응이 중요합니다.
